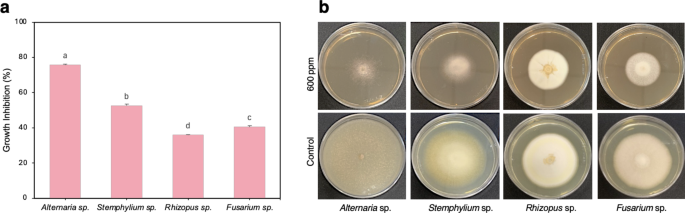
figure 5

Abstract
The synthesis of nanomaterials from PGPB is an exciting approach and it’s often used in agriculture as nano-fertilizers and nano-pesticides. The present study reports a new approach to biosynthesis of silver nanoparticles (AgNP), using bacterial metabolites as agents to reduce Ag+, which will remain as coating agents able to prevent microbial growth. Silver NP were biosynthesized using the bacterial metabolites produced by the beneficial strain Pseudomonas sp. N5.12. Optimization of physicochemical parameters (temperature, pH, and AgNO3 concentration) for the synthesis of AgNP was carried out. In each condition, success on AgNP synthesis was determined by UV–Visible spectra showing peaks between 400 and 450 nm. TEM analysis showed that the AgNP are spherical in shape with an average particle size ranging from 13.75 ± 0.47 nm to 20.71 ± 0.43 nm, covered with a unique organic matter corona of bacterial metabolites. The best parameters for AgNP biosynthesis by Pseudomonas sp. N5.12 occurred with 24 h bacterial metabolites, temperature of 37 °C, pH 9 and a ratio of 2:4 (v: v; bacterial supernatant: 1 mM AgNO3). The biosynthesized AgNP inhibited growth of human pathogenic bacteria better than equivalent AgNO3 concentration. Growth of bacterial and fungal phytopathogens was also inhibited with striking effects on Alternaria sp. (74% inhibition) and Stemphylium sp. (52% inhibition), appearing as promising tools to biocontrol fungal diseases in agriculture.
Similar content being viewed by others
Introduction
Nanotechnology appears as an exciting field of research dealing with an array of nanomaterials of different shape, size and compositions with applications in several fields, varying from medicine to agriculture1. Nanoparticles (NP) are defined as ultrafine organic and inorganic materials, between 1 and 100 nm, that share the presence of a reduced metal. Among the different metals like iron, zinc, gold, silver, selenium, and nickel that are being explored for synthesis of NPs, silver has the advantage of chemical inertness, easy reduction, electrical conductivity, biosensor capacity and wide implementation as antimicrobial agent formulated as silver nanoparticles (AgNP). Hence, AgNP have been established in biomedical and biological applications as one of the promising nanoparticles due to their unique physical and chemical properties2. AgNP have antibacterial properties and are well known as an effective disinfectant against a wide range of microorganisms and can also treat bacterial infections through longer exposure times due to their good stability3. A large number of Gram-positive and Gram-negative bacteria, fungi and viruses are sensitive to AgNP4,5. The proposed mechanism of action6 of AgNP is based on the ability of NP to release of Ag+ions; these ions interact with membranes altering cell homeostasis, penetrate cells where interactions with biomolecules occur directly or as a result to concomitant reactive oxygen species increase7. However, their ability to partly destroy pathogen membrane has recently been reported8. So far, these mechanisms refer to non-biologically synthesised AgNP.
The synthesis methods of AgNP are diverse, including physical, chemical, and biological (green) synthesis approaches. Biological synthesis of NPs using bacteria, fungi, algae and plants has emerged as a fascinating alternative to physical and chemical methods due to biocompatibility, self-reducing, capping and stabilizing abilities9. The biological synthesis of AgNP is an environmentally friendly and sustainable method, with low cost, low energy consumption and has shown great potential in various fields. Most of the green synthesis is carried out with plant extracts because plants contain many antioxidant molecules (polyphenols, terpenes, favonoids, carboxylic acids, saponins, alcohols and tannins). Plant material, such as leaves, stems, roots, shoots, flowers, barks, seeds and their metabolites have been successfully used5.
In addition, bacterial cells are potent “nanofactories” that have been used for the synthesis of various metallic nanoparticles using both intracellular and extracellular routes, although not all bacteria qualify for this purpose. The extracellular route is preferred as there are no downstream processes required for isolation of the final product. Cell-free extracts, bacterial biomass, culture supernatant can be used for extracellular synthesis of nanoparticles. In recent years, the potential of biosynthesis of AgNP using various bacteria has been reported5,10. These AgNP have spherical, disk, cube, hexagonal or triangular shapes. The AgNP resulting from each synthetic conditions are unique due to its size, shape, surface area, dispersibility, absorptivity, reactivity and, on top of that, to the unique surface coating. Therefore, using metabolites of specific bacterial strains will result in unique effects due to the bacterial strain metabolites, and enhanced effects due to the small AgNP size. An interesting group of beneficial bacteria are Plant Growth Promoting Bacteria (PGPB), with reported effects to increase plant yield by activating plant metabolism, improving nutrient availability or inhibiting fungal and bacterial growth, preventing therefore disease onset11,12. There are previous studies reporting successful AgNP with PGPB, all yielding different type of AgNP13,14,15,16,17,18.
Accordingly, we reasoned that the beneficial strain PseudomonasN5.12, would be an interesting candidate for NPs synthesis if the bacterial metabolites able to trigger plant metabolism and control pathogen growth were present in the coating material, creating a NPs with unique properties. As bacterial and fungal pathogens threaten not only human health but also compromise agronomic yield, this uniqueness makes them an excellent material for agriculture19. Hence, the present work explores the ability of bacterial metabolites from the PGPB Pseudomonas sp. N5.12 strain to reduce silver, synthetizing AgNP, and their ability to inhibit growth of human pathogenic bacterial and bacterial and fungal phytopathogens. To achieve this objective, the best conditions for biosynthesis, physicochemical characterization and in vitro antibacterial and antifungal activity was evaluated.
Results
Biosynthesis and characterization of AgNP
AgNP were synthesized by incubation of 1 mM AgNO3 with culture supernatant of PGPB Pseudomonas sp. N5.12 indicated by the color change of the mixture from light yellow to dark brown; as different volumes of AgNO3/supernatant were used, NP are referred to as S1 (1 vol AgNO3 /5 vol supernatant) through S5 (5 vol AgNO3 /1 vol supernatant). To further confirm the synthesis of AgNP, the UV–vis spectrum was analyzed detecting peaks between 400 and 450 nm, corresponding to the excitation of the surface plasmon resonance of Ag0. The maximum wavelength bands corresponding to the different AgNO3 /supernatant ratios shifted to larger wavelengths, from 430 to 460 nm. Supernatants filtered after 24–72 h of growing bacteria were also checked for AgNP synthesis resulting in a better performance of the 24-hour supernatant which was selected for further synthesis (Fig. 1 supplementary material). Nucleation reaction temperature greatly influenced the growth of NPs with specific shapes and sizes (Fig. 1 supplementary material) being 37оC better for synthesis of AgNP than 28оC; therefore, 37оC was chosen for further research. The size and morphology of AgNP depends on pH to a great extent, therefore, the effect of pH in the range of 5–9 was studied to optimize parameters for AgNP synthesis. Twenty-four h supernatant at pH5 were not able to reduce Ag+ ions as no absorption peak at 420 nm was observed (data not shown). After increasing the pH in neutral and alkaline medium (pH 7 and 9), the absorption peak was in the range 400 to 460 nm, indicating the successful synthesis of AgNP. The size and morphology of AgNP synthesized at pH 7 and 9, with all different AgNO3 ratios (S1 to S5) were observed using TEM microscopy (Fig. 1).
The TEM images and histogram of the particle size distribution of AgNP synthesized at pH 7 (a) and pH 9 (b). S1-S5 – different ratio of bacterial supernatant and 1 mM AgNO3 solution S1 (5:1), S2 (4:2), S3 (3:3), S4 (2:4), S5 (1:5). The results were recorded as mean ± SD of the total number 200 for each sample. Bar: 200 nm.
The results indicated that the biosynthesized AgNP were mostly a spherical shape and the average size ranged from 14.2 ± 0.34 nm to 16.68 ± 0.38 nm for pH 7, and from 13.75 ± 0.47 nm to 20.71 ± 0.43 nm for pH9. The size, morphology, and distribution of AgNP at different initial concentrations of AgNO3 are shown in Fig. 1. Since sample 5 was unstable and precipitated due to the high content of silver nitrate (1:5), it wasn´t used further. Moreover, as the size of the NPs was similar at pH7 and pH9, but the absorption peaks were better in the alkaline medium, samples synthesized at pH9 were selected to continue the study. Two samples (S1 and S4), pH9, with the lowest and highest AgNO3 ratios, were used for further characterization.
FTIR analyses for identification of functional groups present in the S1 and S4 Pseudomonas sp. N5.12 AgNP as well as on raw nutrient broth and supernatant (Fig. 2; Table 1). Overlapping of the 3 elements in each condition revealed different profiles with similar patterns, suggesting a unique coating for AgNP. The main bands of the AgNP spectra would correspond to vibrations of protein bonds (3298–3391 cm−1 and 1646–1649 cm−1 regions) and carbohydrates (1098–1386 cm−1 region), with minor contributions of other biomolecules (https://instanano.com/all/characterization/ftir/ftir-functional-group-search/).
The XRD spectrum of the product showed the characteristic Bragg reflection peaks at 2θ values of 27.83o, 32.25o, 38.07o, 46.32o, 54.89o and 57.46o. These peaks associated with a face-centered cubic structure of AgCl crystals (Ref. no. 31–1238), thereby confirming the crystalline properties AgNP. Samples 1 and 4 had the same peaks which differed only in the intensity level of these peaks consistent with the higher Ag concentration (Fig. 3).
Antibacterial and antifungal activity of AgNP
Two selected AgNP samples (S1 and S4, pH9) were tested for their antimicrobial activity against human pathogenic bacteria such as Staphylococcus aureus, S. epidermidis, Enterococcus sp., Salmonella sp., P. aeruginosa and Escherichia coli. The antibacterial effect was evaluated based on the diameter of the growth inhibition zone at different concentration of NPs and the results are shown in Fig. 4. AgNP were found to have a good inhibitory effect on bacterial growth even when using a 10% NPs solution compared to equivalent 1mM AgNO3. The inhibitory effect of the antibiotic standard (gentamicin 10 μm/mL) was significantly higher (p < 0.05) than AgNO3 controls or bacterial supernatants (Table 2).
Antimicrobial activity was high and concentration-dependent for both samples of NPs in all tested bacterial strains (Fig. 4a); a slightly better effect was observed when using AgNP/S4 (ratio 2:4). Pathogen growth inhibition by AgNP was dependent on the bacterial species; inhibition was always more intense than the equivalent AgNO3 concentration, except at the lowest concentration (10%). When using stock concentration (100%), growth inhibition ranged from 13.3 to 21.6% for AgNP/S1, and from 11.6 to 31.7% for AgNP/S4. Enterococcus sp. was the most sensitive species in both cases. As S4 was more effective than S1, a comparative analysis of the inhibitory effect of AgNP/S4 at the highest concentration between gram-negative and gram-positive strains was carried out, finding significant differences among the gram-negative only, being P. aeruginosa the most sensitive (Fig. 4b). The ability of biosynthesized AgNP to restrict growth of the pathogenic strains has been evidenced.
In addition, we tested our AgNP for their antimicrobial activity against pathogenic phytobacteria (Xanthomonas campestris pv. oryzae, X. campestris pv. tomato and P. syringae DC3000). AgNP also showed inhibitory effect on the tested pathogens, but to a lesser extent than on the human pathogenic strains (Table 2). Again, AgNP/S4 showed better antimicrobial effect than AgNP/S1. Higher concentrations (50%, 100%) significantly inhibited bacterial growth as compared to AgNO3 controls (Fig. 4c). X. campestris pv oryzae was most sensitive to AgNP/S1 (28.1% less growth) while AgNP/S4 were more effective on X. campestris pv. tomato, preventing growth (26.7 to 39.2%) depending on the concentration. These results confirm the dose-dependent antibacterial effect of the studied AgNP. The order of the highest antibacterial activity among plant pathogenic bacteria is X. campestris pv. oryzae > X. campestris pv. tomato > P. syringae DC3000.
The mean diameter of inhibition zones by AgNP: (а) different human pathogenic bacteria; (b) different types of bacteria by AgNP/S4 100%; (c) plant pathogenic bacteria. The results were recorded as mean ± SD of the triplicate experiment. Different letters indicate significant differences according to LSD (p < 0.05).
The antifungal activity of AgNP was evaluated in triplicate on four common phytopathogenic strains, as Alternaria sp., Stemphylium sp., Rhizopus sp. and Fusarium sp. The results showed that the inhibition of the mycelial growth caused by AgNP varies depending on the fungal species, concentration and type of NPs (S1 or S4) (Table 3). At 60 ppm, all fungi tested achieved less than 10% inhibition. At high concentrations (600 ppm) AgNP/S1 showed good inhibitory activity, being most effective on Alternaria (41.4 ± 1.6%) sp. AgNP/S4 were more efficient (Fig. 5). With the highest dose (600 ppm), the most sensitive was Alternaria sp., (75.7 ± 0.56% growth inhibition), followed by Stemphylium sp. (52.57 ± 0.95%), Fusarium sp. (40.52% ± 0.65) and Rhizopus sp. (35.86% ± 0.30).
Discussion
The biocontrol capacity of certain Plant growth promoting rhizobacteria of the Pseudomonas genera has been reported before and is usually associated to a plethora of secondary metabolites, siderophores or lipopeptides20. In this work, we used the metabolites of the siderophore-producing plant growth-stimulating Pseudomonas sp. N5.12 for biological synthesis of AgNP, determining the best conditions for synthesis, and explored the NP´s ability to control bacterial and fungal growth. Biological synthesis of AgNP has gained popularity as a potential alternative to other chemical and physical methods, being plant extracts preferred for their high antioxidant potential. However, microorganisms can accumulate and detoxify heavy metals due to the presence of various cytoplasmic reductase enzymes as well as various metabolites released by bacteria, being both effective in the formation of AgNP, creating unique NP depending on metabolites21. In recent research, bacteria such as P. aeruginosa, P. canadensis, Bacillus zanthoxyli GBE11, B. subtilis and E. coli have been shown to be able to synthesize AgNP22,23,24,25. In this work, we used the plant growth-stimulating bacteria Pseudomonas sp. N5.12 for biological synthesis of AgNP, which exhibited a yellowish-brown color from the excitation of surface plasmon vibrations of metal NPs in all evaluated conditions. Surface plasmon vibrations are caused by dipole oscillations which arise as a result of the combination of electromagnetic field oscillations in the visible range with collective oscillations of conduction electrons26. The absorbance peak at 400–450 nm in the UV-visible spectrum corresponded to the typical band of AgNP generated by the ability of bacterial metabolites to reduce Ag+ [13,23]. According to TEM data (Fig. 1), the biosynthesized AgNP had a spherical form with a size range of 13.8 to 20.7 nm being the differences in nanoparticle size due to pH and AgNO3concentration13,14,23. Setting the variables for nucleation (temperature, incubation time and pH) is key for the final properties of the AgNP, with reported nucleation time ranges from 24 to 200 h, temperature ranges from 25 to 50 °C, and pH 4–9 when using bacterial filtrates from other Pseudomonas sp (Table 4). Regarding which of these factors would be more relevant in the process, based on our experience, pH would be of primary influence as it would be determining the charge of specific organic groups present in bacterial metabolites capable of reducing Ag+ as shown by preliminary data showing that pH5 results in total failure of the process, while pH7 and pH9 contribute to successful synthesis. Nevertheless, presence of presence of bacterial enzymes among these metabolites cannot be ruled out either, and all evaluated factors determine enzyme performance potentially involved in Ag+reduction. The importance of synthesis conditions may vary depending on the biological material used for NP synthesis. Different matrices may require different initial conditions to achieve optimal biological NP formation1,2. The effectiveness of these conditions can vary not only between species but also within different strains. Therefore, while pH is effective for Pseudomonas N5.12, other factors, such as temperature, time, or metal concentration, may be crucial for nanoparticle synthesis for another biological sources. Therefore, setting conditions for the synthesis are very important, and the resulting AgNP will differ in their characteristics, even if they are synthesized from the same genus of bacteria (Table 4, and references therein).
In addition to size and shape, the biomolecules responsible for the capping and stabilizing of nanoparticles make NP unique. According to FTIR analysis, we confirmed that AgNP are surrounded by a corona of organic compounds. The main bands of the AgNP spectra would correspond to vibrations of protein bonds (3298–3391 cm−1 and 1646–1649 cm−1 regions) and carbohydrates (1098–1386 cm−1 region), with minor contributions of other biomolecules; a band was observed at 803 cm−1 unique to S4 AgNP (Fig. 2). The free amine and carbonyl groups present in the bacterial protein could possibly perform the function for the formation and stabilization of AgNP. FTIR studies of other synthesized green AgNP have reported different types of compounds, but in most cases proteins and lipids are found to be present13,29. These results suggest that, although different conditions of synthesis are used (S1 and S4), AgNP tend to be surrounded by the same kind of organic compounds (Table 1). Probably, differences in corona components exist, in terms of the proportion of each type of a particular compound, producing properties that may diversify its functionality. The crystalline nature of silver was confirmed by XDR analysis showing five diffractions peaks that correspond to the face-centered cubic structure of AgCl crystals. Previous research that demonstrated the creation of AgNP utilizing microbes had comparable XRD results29,33. The detection of AgCl on XRD is explained by the presence of NaCl in the broths used in the synthesis of NPs.
Prior to evaluation of antibacterial potential, the number of different AgNP obtained was narrowed down to 2 types, assuming from the beginning that the bacterial metabolites were the key to this process. We were looking for the best NP, based on (i) size, to ensure effectiveness, and (ii) coated with metabolites, to provide a new interesting approach to NP. As metabolites were always present in all conditions, we selected pH9 over pH7 for intensity of reaction (UV-spectrum), and among those, we chose the two NP most different in size and Ag content to test antimicrobial potential, assuming that intermediate condition would not represent a big difference.
AgNP are the most investigated antibacterial agents against various bacterial and fungal pathogens, both relevant for human and plant health34. The true relevance of this enhanced antibacterial potential of AgNP relies on the expectation to control growth of multi drug resistant strains, which limit the ability to control disease spread. When talking about agriculture, bacterial pathogens account for 16% yield losses, while fungal pathogens are responsible for up to 80% loss in yield35, compromising food availability, despite the many chemicals used for this purpose. Hence, finding effective alternatives to cope with this challenge is of paramount importance.
The present study showed that all the studied human pathogenic strains were sensitive to N5.12 unique AgNP, being Gram-negative bacteria strains more sensitive. Consistent with previous reports the stronger inhibitory effect on Gram-negative is due to differences in cell wall composition36,37. Moreover, our NPs also showed antibacterial activity against phytopathogenic bacteria, especially relevant in S4 AgNP (Fig. 4c; Table 2). The reported mechanisms of action to inhibit bacterial growth consist in interaction with the outer bacterial membrane. AgNP easily adhere to the cell wall and cytoplasmic membrane due to electrostatic attraction and their accumulation on surface of membrane. As a result, the permeability of the bacterial membrane is disturbed which leads to the destruction of cells38. The intracellular action of silver ions consists in the deactivation of the respiratory enzymes and generation reactive oxygen species which leads to DNA modification. AgNP interact with sulfur and phosphorus in DNA which can cause damage to DNA replication and cell death39. However, these mechanisms necessary imply that the AgNP behaves as a source of Ag ions, which is determined to an unknown extent by the capping agents that conform the corona40. According to our results (Fig. 4; Table 2), and inhibition was higher than AgNO3 equivalent concentration, hence speaking of an effective corona composition able to biocontrol bacterial phytopathogens, other than the ion-effects. Hence, the exact mechanism by which N5.12 AgNP control bacterial and fungal growth is probably based in specific bacterial active molecules present in the corona and is yet to be determined.
Interestingly, NP controlled Stemphylium growth by 52.6% (Fig. 5; Table 2); considering that this fungi compromises crop yield i.e. onion yield by 90%41, lentil by 100%42or sugar beet43 among others, this result is a very interesting active matter for agriculture. Similarly, this may benefit other crops which are affected by Alternaria sp., which is also controlled even to a greater extent (75%)44. The least efficiency of AgNP was observed against F. oxysporum (68%) inhibition of colony formation. Despite of the minor inhibition on Fusarium, N5.12 AgNP would be an excellent tool when no other products are available. Thus, AgNP exhibited strong antifungal effects on tested fungi and biosynthesized AgNP can be applied effectively in the control of phytopathogens and the prevention of deleterious infections.
In view of the inhibitory potential of N5.12 AgNP, and before developing a product for agriculture, it is convenient to raise concern about the potential risk for the environment. Further experimental work is necessary to evaluate the potential risk for agriculture. However, as the corona is made of metabolites from beneficial rhizobacterial strains, a low risk for the environment is anticipated.
AgNPs are proposed as antimicrobial agents in agriculture but evaluating their cost-effectiveness and feasibility for large-scale application must be addressed. AgNPs must also be durable and effective in diverse agricultural environments to be cost-efficient. Potential barriers to widespread adoption include environmental and regulatory concerns, particularly regarding soil health and microbial communities. Public perception and competition from traditional pesticides or organic alternatives may also hinder their use. Additionally, the infrastructure required for large-scale production, distribution, and application adds complexity and cost. In summary, while AgNPs show promise, their large-scale adoption will depend on overcoming production challenges, regulatory approval, and integration into existing agricultural practices. On the other hand, and looking into circular economy, this technology represents an advantage to industries devoted to production of biostimulants and biofertilizants. These industries produce high volumes of fermentation by-products as they only use bacterial cell for marketable microbial products. Once cells are removed, metabolites need to be eliminated. Using them for NP is a process to increase company value, creating innovative products, probably next-generation antimicrobials.
In summary, bacterial metabolites of the PGPB Pseudomonas sp. N5.12 have been able to reduce Ag+, resulting in biological synthesis of AgNP, for which the best synthesis conditions were determined. Characterization of the AgNP revealed 13 to 20 nm spherical AgNP, with a unique composition of the organic corona, which is related to their antibacterial activity against human and plant pathogens. Based on the obtained results of antibacterial activity, the potential use of these AgNP as a means of control against human pathogens is possible, but its applications for agriculture foresee great success based on antifungal activity.
Materials and methods
Preparation of Pseudomonassp. N5.12 strain culture.
Pseudomonas sp. N5.12 was isolated from the rhizosphere of Nicotiana glaucain Almeria, Spain45. The bacterial strain was periodically cultured and maintained in plate count agar (PCA). For biosynthesis of AgNP, Pseudomonas sp. was grown in nutrient broth (NB, Pronadisa Spain) at 28 °C in an orbital shaker, at 150 rpm, for 24, 48 and 72 h. The bacterial culture was centrifuged at 5000 rpm for 20 min using a refrigerated centrifuge (AFI LISA MultiLab Centrifuge, France). The pellet was discarded, and the supernatant was filtered by 0.25 mm (VWR International, USA) and used for the extracellular synthesis AgNP. Cell-free culture supernatant of Pseudomonas sp. N5.12 was confirmed by no bacterial growth after incubating 100 µL of supernatants on nutrient agar at 28 °C for 24 h.
Biosynthesis of AgNP
The following variables were considered to determine the optimal conditions for NPs biosynthesis: pH (5, 7, 9), ratio supernatant/AgNO3 (v: v, (5:1, 4:2, 3:3, 2:4 and 1:5), and nucleation temperature (28–37ºC). The culture supernatants were adjusted to corresponding pH. Then, supernatants were mixed with 1 mM AgNOз aqueous solution in different ratios. Flasks were incubated for 24 h orbital shaker at 150 rpm under continuous light conditions; nutrient broth with AgNOз solution used as control, to rule out presence of reducing metabolites as medium components. After incubation period, the AgNP were collected by centrifugation at 5000 rpm for 20 min (AFI LISA MultiLab Centrifuge, France) and washed thoroughly with miliQ water to remove the unconverted metal ions or any other constituents, stopping nucleation. Presence of NPs was confirmed by UV absorption as described below. The purified AgNP were freeze-dried and liophylized to obtain a powder. A stock solution dissolved in 1 mL distilled water was prepared for further characterization and application in antimicrobial activity experiments. The procedure for the biosynthesis of AgNPs, with all conditions outlined, is presented in Fig. 2S (supplementary material).
Characterization of synthesized AgNP
The bioreduction of the Ag+ ions in the solution were observed by changes in color from light yellow to dark brown. The absorption spectrum of this solution was monitored by UV–Visible spectrometry from 200 to 800 nm at 1 nm resolution using a SPECTROstar Nano spectrometer (BMG LABTECH, Germany) confirming presence of Ag0 by increased absorption at 420–450 nm.
Size distribution and morphology of synthesized AgNP were estimated by TEM. The equipment is Thermo Fisher Scientific Prisma E and xT Microscope Control v16.2.2 software. The measurements have been carried out by depositing a few drops of the sample in suspension on aluminum and magnesium sample holders, allowing it to dry before placing it in the microscopes. In the black and white images, topography, we have worked with the Everhart Thornley Detector (ETD) of secondary electrons at 30 kV and spot 2.0 (= 24 pA). Analyses were carried out at ICTS-CNME (https://cnme.es/).
Functional groups responsible for the synthesis and stabilization of AgNP were detected by Fourier transform infrared (FTIR) spectroscopy, on KBr pellets. The samples were scanned using a Spectrum Two FTIR Spectrometers (Perkin Elmer) with a resolution of 4 cm−1 and a range of 450–4000 cm−1. Analyses were carried out at SIDI (https://www.uam.es/uam/en/sidi/unidades-de-analisis/unidad-analisis-estructural-molecular/ftir).
The lyophilized samples of the biosynthesized AgNP coated on XRD grids were studied for X-ray diffraction patterns using a Bruker D8 diffractometer and a fast detector LynxEye, operating at a voltage of 40 kV and current of 40 mA with a scan rate of 0.01/s (https://www.uspceu.com/investigacion/servicios-apoyo/servicio/difracci%C3%B3n-de-rayos-x).
Antibacterial activity of AgNP
The antibacterial disk diffusion assay on antibacterial activity of biosynthesized AgNP was evaluated using the Kirby-Bauer technique46. Three Gram-negative (Salmonella sp., Escherichia coli and Pseudomonas aeruginosa) and three Gram-positive (Enterococcus sp., Staphylococcus epidermidis and Staphylococcus aureus) human pathogen bacterial strains were used in this study. Also, three phytobacteria were tested in this study: Xanthomonas campestris pv. oryzae, X. campestris pv. tomato and P. syringae DC3000.
Mueller Hinton Agar (MHA) was used for the analysis of antibacterial activity on disposable sterile Petri dishes and stored in the refrigerator at 4 °C for further use. Gentamicin (10 µg/mL), AgNO3 1mM solution in equivalent concentrations to NP, and cell-free culture supernatant of Pseudomonas sp. N5.12 were used as positive and negative controls. The bacterial pathogen suspension was prepared by subculturing bacteria into NB medium. The human pathogenic bacteria were incubated for 24 h in orbital shaker at 150 rpm for 37 °C; phytopathogenic bacteria were incubated at 28ºC. The optical density OD600 of the bacterial suspension was adjusted to 0.1 absorbance at 600 nm, that corresponds to 1.5 × 106 cfu/mL. The inoculum with bacteria culture (100 µL) was then spread evenly over the MHA plate using a sterile disposable spatula. Paper discs (6 mm) containing 30 µL of the AgNP at different concentrations (10, 25, 50, 75 and 100%) were placed on the center of the petri dishes. The diameter of the growth of each bacteria was measured by digital image analysis using ImageJ software (Version 1.8.0_345). The results were recorded as the mean ± standard deviation of the triplicate experiment. The experiment was carried out in triplicate and measurements were made after 24 h of incubation at 37 °C for human pathogens while phytopathogens were incubated at 28ºC.
Antifungal activity of AgNP
The effect of AgNP was studied on Fusarium sp., Stemphylium sp., Alternaria sp. and Rhizopus sp. fungi. The Potato-Dextrose-Agar (PDA) culture medium was prepared, sterilized and stored in the refrigerator at 4 °C for further use. AgNP were added to the medium at concentrations of 60 and 600 ppm. A PDA disk with fresh fungal mycelium of 0.5 cm in diameter, was placed in the center of each Petri dish with NPs in the medium; plates were incubated at room temperature, in the dark, until mycelial growth in controls covered the surface, variable according to each fungus. The diameter of the growth of each fungus was measured by digital image analysis using ImageJ software (Version 1.8.0_345). The mycelial growth was measured in every Petri dish after 5 days after incubation for Alternaria and Stemphylium spp. and 12 days after incubation for Fusarium and Rhizopus spp. The percentage of mycelial growth inhibition was calculated using the following equation proposed by47: Inhibition% = (DCC − DCP)/DCC × 100%, where: DCC – diameter of the control colony (cm); DCP – diameter of the problem colony (fungus in the presence of AgNP) (cm). Each treatment had three replicates.
Statistical analysis
All antimicrobial experiments were conducted in three independent replicated and the results were stated as the mean ± standard deviation (mean ± SD) analyzing by one-way analysis of variance (ANOVA) between the obtained values (p < 0.05) and LSD post hoc test. The statistical data analysis was analyzed using IBM SPSS Statistics (Version 29.0.2.0). Values of p < 0.05 indicated the significant differences.
Data availability
The datasets generated and/or analysed during the current study are available in the Zenodo repository, https://doi.org/10.5281/zenodo.14051744.
References
Nie, P., Zhao, Y. & Xu, H. Synthesis, applications, toxicity and toxicity mechanisms of silver nanoparticles: a review. Ecotoxicol. Environ. Saf. 253, 114636. https://doi.org/10.1016/j.ecoenv.2023.114636 (2023).
Mohammadlou, M., Maghsoudi, H. & Jafarizadeh, H. A review on green silver nanoparticles based on plants: synthesis, potential applications and eco-friendly approach. Int. Food Res. J. 23, 446–463 (2016).
Li, H. et al. A comparative study of the antibacterial mechanisms of silver ion and silver nanoparticles by Fourier transform infrared spectroscopy. Vib. Spectrosc. 85, 112–121. https://doi.org/10.1016/j.vibspec.2016.04.007 (2016).
Liao, C., Li, Y. & Tjong, S. C. Bactericidal and cytotoxic properties of silver nanoparticles. Int. J. Mol. Sci. 20 (2), 449. https://doi.org/10.3390/ijms20020449 (2019).
Siddiqi, K. S., Husen, A. & Rao, R. A. K. A review on biosynthesis of silver nanoparticles and their biocidal properties. J. Nanobiotechnol. 16, 14. https://doi.org/10.1186/s12951-018-0334-5 (2018).
Dakal, T. C., Kumar, A., Majumdar, R. S. & Yadav, V. Mechanistic basis of antimicrobial actions of silver nanoparticles. Front. Microbiol. 7, 1831. https://doi.org/10.3389/fmicb.2016.01831 (2016).
Wu, Y. et al. A facile method to prepare size-tunable silver nanoparticles and its antibacterial mechanism. Adv. Powder Technol. 29 (2), 407–415. https://doi.org/10.1016/j.apt.2017.11.028 (2018).
Jiang, L. et al. Biosynthesized silver nanoparticles inhibit Pseudomonas syringae Pv. Tabaci by directly destroying bacteria and inducing plant resistance in Nicotiana Benthamiana. Phytopathol. Res. 4, 43. https://doi.org/10.1186/s42483-022-00148-8 (2022).
Ovais, M. et al. Role of plant phytochemicals and microbial enzymes in biosynthesis of metallic nanoparticles. Appl. Microbiol. Biotechnol. 102, 6799–6814. https://doi.org/10.1007/s00253-018-9146-7 (2018).
Ansari, M. A. & Rehman, S. (eds) Microbial Nanotechnology: Green Synthesis and Applications (Springer, 2021). https://doi.org/10.1007/978-981-16-1923-6
Aguirre-Becerra, H. et al. Nanomaterials as an alternative to increase plant resistance to abiotic stresses. Front. Plant. Sci. 13, 1023636. https://doi.org/10.3389/fpls.2022.1023636 (2022).
Mohanty, P., Singh, P. K., Chakraborty, D., Mishra, S. & Pattnaik, R. Insight into the role of PGPR in sustainable agriculture and environment. Front. Sustain. Food Syst. 5, 667150. https://doi.org/10.3389/fsufs.2021.667150 (2021).
Hossain, A. et al. Green synthesis of silver nanoparticles with culture supernatant of a bacterium Pseudomonas rhodesiae and their antibacterial activity against soft rot pathogen Dickeya dadantii. Molecules 24 (12), 2303. https://doi.org/10.3390/molecules24122303 (2019).
Singh, J. et al. Green’ synthesis of metals and their oxide nanoparticles: applications for environmental remediation. J. Nanobiotechnol. 16, 84. https://doi.org/10.1186/s12951-018-0408-4 (2018).
Kalaimurugan, D. et al. Larvicidal activity of silver nanoparticles synthesized by Pseudomonas fluorescens YPS3 isolated from the eastern ghats of India. J. Clust Sci. 30, 225–233. https://doi.org/10.1007/s10876-018-1478-z (2019).
Sodimalla, T. & Yalavarthi, N. Biosynthesis of silver nanoparticles from Pseudomonas fluorescens and their antifungal activity against Aspergillus Niger and Fusarium Udum. Ann. Appl. Biol. 181, 235–245. https://doi.org/10.21203/rs.3.rs-942499/v1 (2022).
Bayoume, A., Elhamid, M., Khalil, M., Ali, A. & Abbas, R. The potential activity of biosynthesized silver nanoparticles of Pseudomonas aeruginosa as an antibacterial agent against multidrug-resistant isolates from intensive care unit and anticancer agent. Environ. Sci. Eur. 34, 109. https://doi.org/10.1186/s12302-022-00684-2 (2022).
Yang, J. et al. Pseudomonas aeruginosa synthesized silver nanoparticles inhibit cell proliferation and induce ROS mediated apoptosis in thyroid cancer cell line (TPC1). Artif. Cells Nanomed. Biotechnol. 48 (1), 800–809. https://doi.org/10.1080/21691401.2019.1687495 (2020).
Mandal, M. & Sarkar, A. Green syntheses of nanoparticles from plant growth–promoting microorganisms and their application in the agri-food industries in Nanotechnology and Nanomaterials in the Agri-Food Industries (eds. Singh, P., Khare, P., Mishra, D., Bilal, M., & Sillanpää, M.) 185–204 (Elsevier, 2024). https://doi.org/10.1016/B978-0-323-99682-2.00010-4
Höfte, M. Burleigh Dodds,. The use of Pseudomonas spp. as bacterial biocontrol agents to control plant disease in Microbial Bioprotectants for Plant Disease Management (eds. Köhl, J., & Ravensberg, W. J.) (2021). https://doi.org/10.19103/AS.2021.0093.11
Singh, M., Srivastava, M., Kumar, A. & Pandey, K. D. Biosynthesis of nanoparticles and applications in agriculture in Role of Plant Growth Promoting Microorganisms in Sustainable Agriculture and Nanotechnology (eds. Kumar, A., Singh, A. K., & Choudhary, K. K.) 199–217 (Woodhead Publishing, 2019). https://doi.org/10.1016/B978-0-12-817004-5.00012-9
Tabassum, N., Khan, F., Jeong, G. J., Jo, D. M. & Kim, Y. M. Silver nanoparticles synthesized from Pseudomonas aeruginosa pyoverdine: antibiofilm and antivirulence agents. Biofilm 7, 100192. https://doi.org/10.1016/j.bioflm.2024.100192 (2024).
Ghasemi, S., Harighi, B. & Ashengroph, M. Biosynthesis of silver nanoparticles using Pseudomonas canadensis, and its antivirulence effects against Pseudomonas tolaasii, mushroom brown blotch agent. Sci. Rep. 13, 3668. https://doi.org/10.1038/s41598-023-30863-x (2023).
Li, Q. et al. Green synthesis of silver nanoparticles using endophytic bacterium Bacillus zanthoxyli GBE11 and their antimicrobial activity. Biomass Convers. Biorefin. 14, 13173–13185. https://doi.org/10.1007/s13399-022-03266-7 (2024).
Mbagwu, F. O., Auta, S. H., Bankole, M. T., Kovo, A. S. & Abioye, O. P. Biosynthesis and characterization of silver nanoparticles using Bacillus subtilis, Escherichia coli, and leaf extracts of Jatropha and Ocimum species. Int. Nano Lett. 13, 63–73. https://doi.org/10.1007/s40089-022-00387-9 (2023).
Kozuch, J., Ataka, K. & Heberle, J. Surface-enhanced infrared absorption spectroscopy. Nat. Rev. Methods Primer. 3, 70. https://doi.org/10.1038/s43586-023-00253-8 (2023).
Pernas-Pleite, C., Conejo-Martínez, A. M., Marín, I. & Abad, J. P. Green extracellular synthesis of silver nanoparticles by Pseudomonas Alloputida, their growth and biofilm-formation inhibitory activities and synergic behavior with three classical antibiotics. Molecules 27 (21), 7589. https://doi.org/10.3390/molecules27217589 (2022).
Abd Alamer, I. S., Tomah, A. A., Ahmed, T., Li, B. & Zhang, J. Biosynthesis of silver chloride nanoparticles by rhizospheric bacteria and their antibacterial activity against phytopathogenic bacterium Ralstonia solanacearum. Molecules 27 (1), 224. https://doi.org/10.3390/molecules27010224 (2022).
Ahsan, T. Biofabrication of silver nanoparticles from Pseudomonas fluorescens to control tobacco mosaic virus. Egypt. J. Biol. Pest Control. 30, 66. https://doi.org/10.1186/s41938-020-00268-3 (2020).
Jo, J. H. et al. Pseudomonas deceptionensis DC5-mediated synthesis of extracellular silver nanoparticles. Artif. Cells Nanomed. Biotechnol. 44, 1576–1581. https://doi.org/10.3109/21691401.2015.1068792 (2016).
Paul, D. & Sinha, S. Extracellular synthesis of silver nanoparticles using Pseudomonas aeruginosa KUPSB12 and its antibacterial activity. Jordan J. Biol. Sci. 7 (4), 245–250. https://doi.org/10.12816/0008246 (2014).
Kumar, C. G. & Mamidyala, S. K. Extracellular synthesis of silver nanoparticles using culture supernatant of Pseudomonas aeruginosa. Colloids Surf. B Biointerfaces. 84 (2), 462–466. https://doi.org/10.1016/j.colsurfb.2011.01.042 (2011).
Jeevan, P., Ramya, K. & Rena, A. Extracellular biosynthesis of silver nanoparticles by culture supernatant of Pseudomonas aeruginosa. Indian J. Biotechnol. 11, 72–76 (2012).
Kutawa, A. B. et al. Trends in nanotechnology and its potentialities to control plant pathogenic fungi: a review. Biology 10 (9), 881. https://doi.org/10.3390/biology10090881 (2021).
Atiq, M. et al. Nanoparticles: a safe way towards fungal diseases. Arch. Phytopathol. Plant. Prot. 53 (17–18), 781–792. https://doi.org/10.1080/03235408.2020.1792599 (2020).
Kędziora, A. et al. Similarities and differences between silver ions and silver in nanoforms as antibacterial agents. Int. J. Mol. Sci. 19 (2), 444. https://doi.org/10.3390/ijms19020444 (2018).
Menichetti, A., Mavridi-Printezi, A., Mordini, D. & Montalti, M. Effect of size, shape and surface functionalization on the antibacterial activity of silver nanoparticles. J. Funct. Biomater. 14 (5), 244. https://doi.org/10.3390/jfb14050244 (2023).
Zheng, K., Setyawati, M. I., Leong, D. T. & Xie, J. Antimicrobial silver nanomaterials. Coord. Chem. Rev. 357, 1–17. https://doi.org/10.1016/j.ccr.2017.11.019 (2018).
More, P. R. et al. Silver nanoparticles: bactericidal and mechanistic approach against drug resistant pathogens. Microorganisms 11 (2), 369. https://doi.org/10.3390/microorganisms11020369 (2023).
Hsueh, Y. H. et al. The antimicrobial properties of silver nanoparticles in Bacillus subtilis are mediated by released Ag+ ions. PLOS ONE. 10, e0144306. https://doi.org/10.1371/journal.pone.0144306 (2015).
Diekmann, M. & Nations, F. & FAO/IBPGR. FAO/IBPGR Technical Guidelines for the safe Movement of Allium Germplasm (International Plant Genetic Resources Institute (IPGRI), 1997).
Subedi, M., Bazghaleh, N., Caudillo-Ruiz, K. & Vandenberg, A. Stemphylium blight reduces milling qualities of lentil. Agron. J. 113 (2), 1909–1919. https://doi.org/10.1002/agj2.20551 (2021).
Hanse, B., Raaijmakers, E. E. M., Schoone, A. H. L. & van Oorschot, P. M. S. Stemphylium sp., the cause of yellow leaf spot disease in sugar beet (Beta vulgaris L.) in the Netherlands. Eur. J. Plant. Pathol. 142, 319–330. https://doi.org/10.1007/s10658-015-0617-8 (2015).
Abdel-Hafez, S. I. I. et al. Assessment of protein silver nanoparticles toxicity against pathogenic Alternaria solani. 3 Biotech 6, 199. (2016). https://doi.org/10.1007/s13205-016-0515-6
Ramos-Solano, B., García, L. & Garcia-Villaraco, J. A. Siderophore and chitinase producing isolates from the rhizosphere of Nicotiana glauca Graham enhance growth and induce systemic resistance in Solanum lycopersicum L. Plant. Soil. 334, 189–197. https://doi.org/10.1007/s11104-010-0371-9 (2010).
Bauer, A. W., Kirby, W. M., Sherris, J. C. & Turck, M. Antibiotic susceptibility testing by a standardized single disk method. Am. J. Clin. Pathol. 45 (4), 493–496 (1966).
Vera-Reyes, I. et al. Inhibition of phytopathogenic and beneficial fungi applying silver nanoparticles in vitro. Molecules 27 (23), 8147. https://doi.org/10.3390/molecules27238147 (2022).
Acknowledgements
We express our gratitude to Paula Rosendo Santos (Universidad San Pablo CEU) for methodological assistance in the XRD analysis. We also thank the services of UAM (Universidad Autónoma de Madrid) and CNME/ICTS (Centro Nacional de Microscopía Electrónica) for providing the facilities for the analysis of synthesized AgNPs, including FTIR and TEM, respectively.
Funding
This work was funded by the Marie Skłodowska-Curie Actions fellowship (MSCA4Ukraine grant number ID1233311).
Author information
Authors and Affiliations
Contributions
Conceptualization, S.P., B.R.-S. and F.J.G.-M.; experimental work and writing-original draft preparation, S.P.; writing-editing, A.G.-V., J.A.L.; supervision, writing–review and editing, B.R.S. and F.J.G.-M. All authors have read and agreed to the published version of the manuscript.
Corresponding authors
Ethics declarations
Competing interests
The authors declare no competing interests.
Additional information
Publisher’s note
Springer Nature remains neutral with regard to jurisdictional claims in published maps and institutional affiliations.
Electronic supplementary material
Below is the link to the electronic supplementary material.
Rights and permissions
Open Access This article is licensed under a Creative Commons Attribution 4.0 International License, which permits use, sharing, adaptation, distribution and reproduction in any medium or format, as long as you give appropriate credit to the original author(s) and the source, provide a link to the Creative Commons licence, and indicate if changes were made. The images or other third party material in this article are included in the article’s Creative Commons licence, unless indicated otherwise in a credit line to the material. If material is not included in the article’s Creative Commons licence and your intended use is not permitted by statutory regulation or exceeds the permitted use, you will need to obtain permission directly from the copyright holder. To view a copy of this licence, visit http://creativecommons.org/licenses/by/4.0/.
About this article
Cite this article
Plokhovska, S., García-Villaraco, A., Lucas, J.A. et al. Silver nanoparticles coated with metabolites of Pseudomonas sp. N5.12 inhibit bacterial pathogens and fungal phytopathogens. Sci Rep 15, 1522 (2025). https://doi.org/10.1038/s41598-024-84503-z
Received:
Accepted:
Published:
Version of record:
DOI: https://doi.org/10.1038/s41598-024-84503-z
Keywords
This article is cited by
-
Integrated genome mining and phytohormone profiling of six plant growth-promoting elite bacterial strains
Archives of Microbiology (2026)
-
Endophyte-mediated biosynthesis of biogenic nanoparticles: mechanisms and biomedical applications
Archives of Microbiology (2026)
-
Microfluidic Platform for Predicting Nanoparticle Dynamics in Cancer Therapeutics
Journal of Fluorescence (2025)
-
Pseudomonas fluorescens–Based Biogenic Silver Nanoparticles: a Green Solution for Brown Leaf Spot Disease in Rice
BioNanoScience (2025)